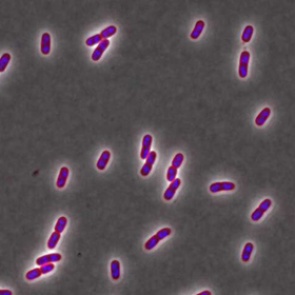
Названа опасность популярных бытовых товаров

Раскрыты подробности первой кибератаки США на Россию 0
28 февраля 2019 - Marishka
| 983 просмотра
Читать далее...
Украина не будет участвовать в Евровидении этого года 0
28 февраля 2019 - Marishka
| 785 просмотров
Читать далее...
Названа опасность популярных бытовых товаров 0
26 февраля 2019 - Marishka
| 879 просмотров
Читать далее...
Трамп захотел закончить торговую войну с Китаем 0
25 февраля 2019 - Marishka
| 846 просмотров
Читать далее...
Представлен первый смартфон с пятью камерами 0
25 февраля 2019 - Marishka
| 813 просмотров
Читать далее...
Богатейшего человека Молдавии обвинили в выводе из России миллиардов рублей 0
22 февраля 2019 - Marishka
| 751 просмотр
Читать далее...
Жертвами пожара в Бангладеш стали более 40 человек 0
21 февраля 2019 - Marishka
| 779 просмотров
Читать далее...
Порошенко снова предупредил о возможной войне с Россией 0
21 февраля 2019 - Marishka
| 766 просмотров
Читать далее...
Трамп задумал узаконить геев во всем мире 0
20 февраля 2019 - Marishka
| 881 просмотр
Читать далее...